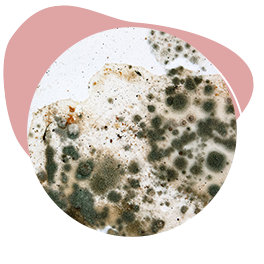

Odour-less Ultra Diamond Matt
Interior Paints

Odour-less Ultra Diamond Matt is an ultra-premium interior paint engineered for lasting beauty. Its advanced formula delivers exceptional stain resistance, making cleaning effortless and ensuring your walls stay fresh and clean. With excellent washability, it helps your walls retain a smooth, consistent matte finish over time.
Odour-less Ultra Diamond Matt

Benefits
![]()
Ultra-low odour
![]()
Excellent washability
![]()
Fungus & mould resistance
Features
![]()
Excellent flow & levelling
![]()
Stain resistance
![]()
Improve air quality with its low emission
![]()
Excellent coverage and hiding power
![]()
Anti-bacterial property
![]()
Free from Alkylphenol Ethoxylate (APEO) & formaldehyde
![]()
Does not contain lead and mercury
![]()
Does not contain heavy metals
Finish
![]()
Soft matt
Use This Paint If...

You want to get rid of harmful formaldehydes

You want to make cleaning effortless with its exceptional stain and burnish resistance
You want a paint that protects against mould, mildew, and bacteria that cause stains on the paint film
Where Can You Use It?
Interior walls and ceilings of hospitals, schools, offices and residential buildings, particularly in high-traffic areas and where a washable finish is desired.
It is also ideal for internal masonry surfaces, such as cement, plastered walls, brickwork and fibre boards.

METHOD:
Roller or brush
THEORETICAL COVERAGE:
DRYING TIME:
Surface Dry – 30 minutes at 30°C
Hard Dry – 1 hours at 30°C
OVERCOATING TIME:
2 hours
Ensure surface is clean, dry and stable using the following suggested surface treatments:
- Moisture: There must not be any water residue on the surface of the substrate. Moisture must be <4% (Sovereign moisture master) before application
- Unstable matter: Remove loose bonding film, dirt, peeling paint, etc by high-pressure water jet wash or mechanical means such as power brush or scraper, whichever is suitable
- Contaminants: Remove dust and foreign matter by cleaning with damp cloth. Remove oil or grease using solvent or mild detergent. Allow surface to dry
- Fungus and Algae: Wash the affected area to remove unstable matters and micro-organisms. Apply Anti-Fungus Solution and leave on for at least 2 hours
- Hairline cracks: Fill cracks with suitable exterior grade water- resistant putty or filler
You might also be interested in
Also bought with
Why Nippon Paint?

Nippon Paint is Singapore's No.1 Paint Brand.

Nippon Paint is one of the most established pioneers in the paint industry with more than 120 years of experience in paint technology.

Nippon Paint strictly complies with local quality, environmental, occupational health and safety, legal and other requirements to ensure highest quality is met.





